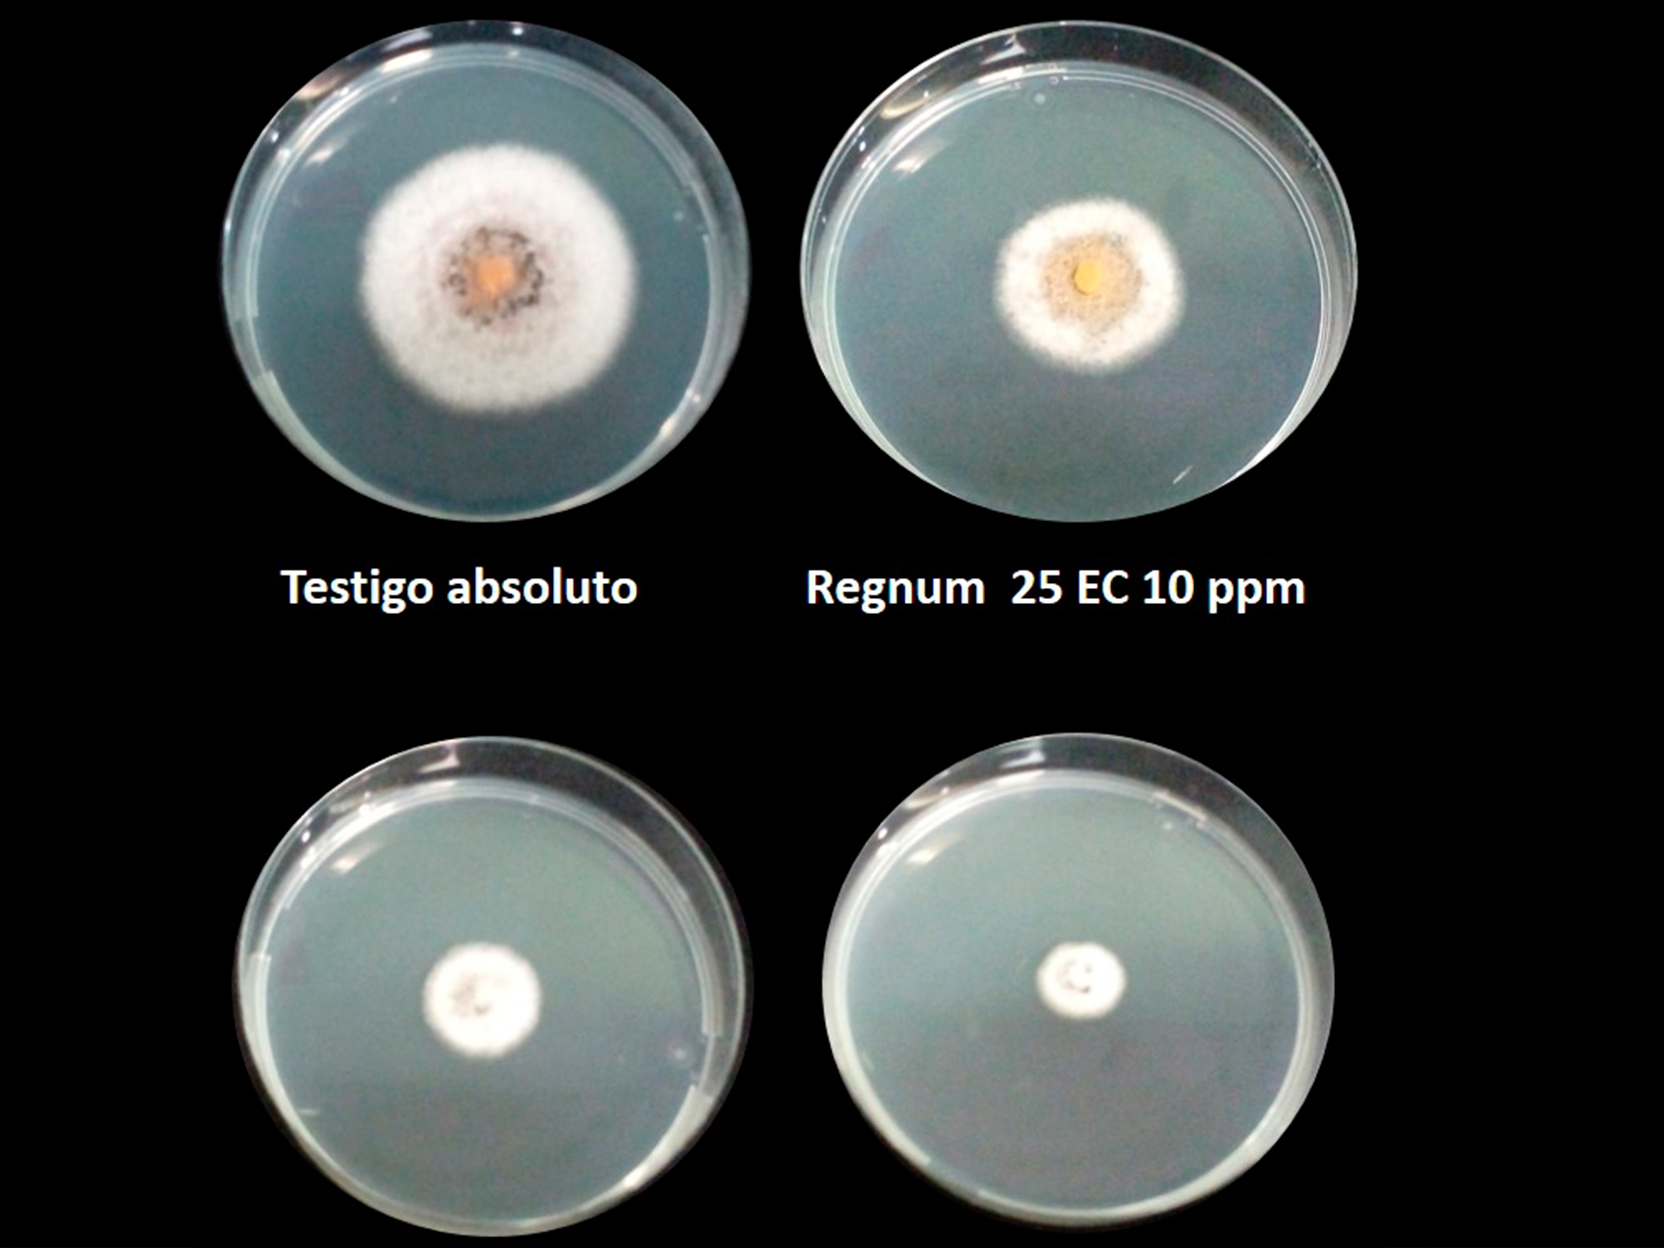

Pruebas de investigación
Generamos información a partir de pruebas fisiológicas y patológicas de laboratorio, invernadero, vivero, campo y post-cosecha. Para ello contamos con una amplia colección de patógenos, con los cuales se puede evaluar la eficacia de productos fitosanitarios, tanto biológicos, botánicos y/o agroquímicos.
Establecemos ensayos de campo en cualquier localidad de Costa Rica, en las zonas agroecológicas idóneas para cada cultivo. En el caso de cultivos como piña y banano, contamos con una estación experimental de 14 ha ubicada en la zona Atlántica. Todos nuestros ensayos son conducidos por profesionales con amplia trayectoria, los cuales cuentan con idoneidad para llevar a cabo investigaciones protocolizadas ante el SFE-MAG, por ende, los ensayos pueden ser avalados por las autoridades nacionales competentes para apoyar los procesos de registro o ampliación de uso de productos.
Nuestros servicios brindan soporte técnico y científico a agricultores, desarrolladores, formuladores y distribuidores, tanto nacionales e internacionales, en sus proyectos de I+D, quienes confían en la calidad y confidencialidad que caracteriza nuestro trabajo. En BIOTECH apoyamos la innovación para el sector agroalimentario.